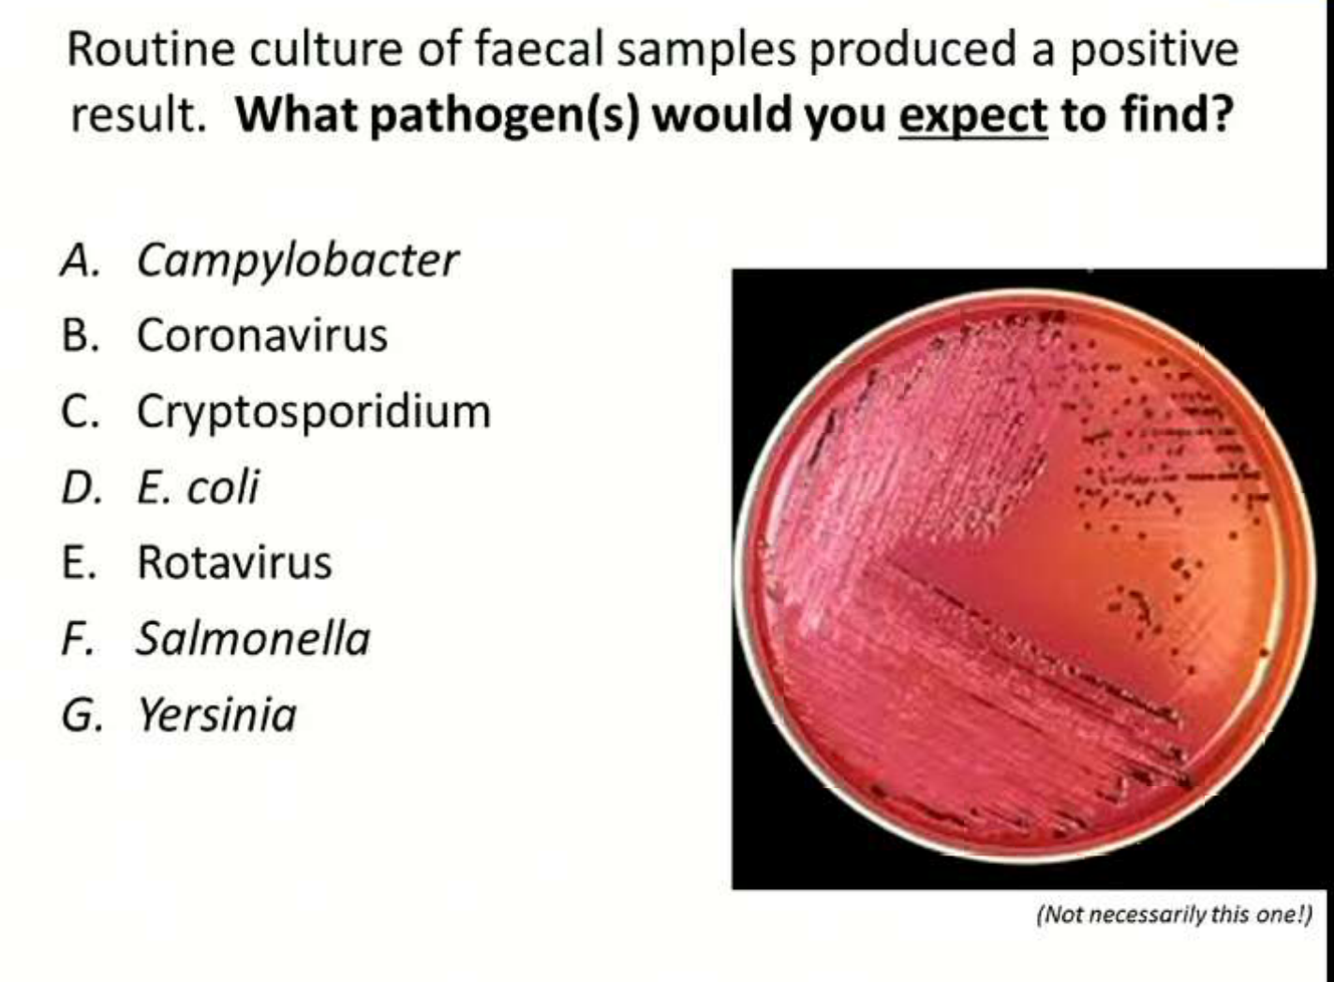
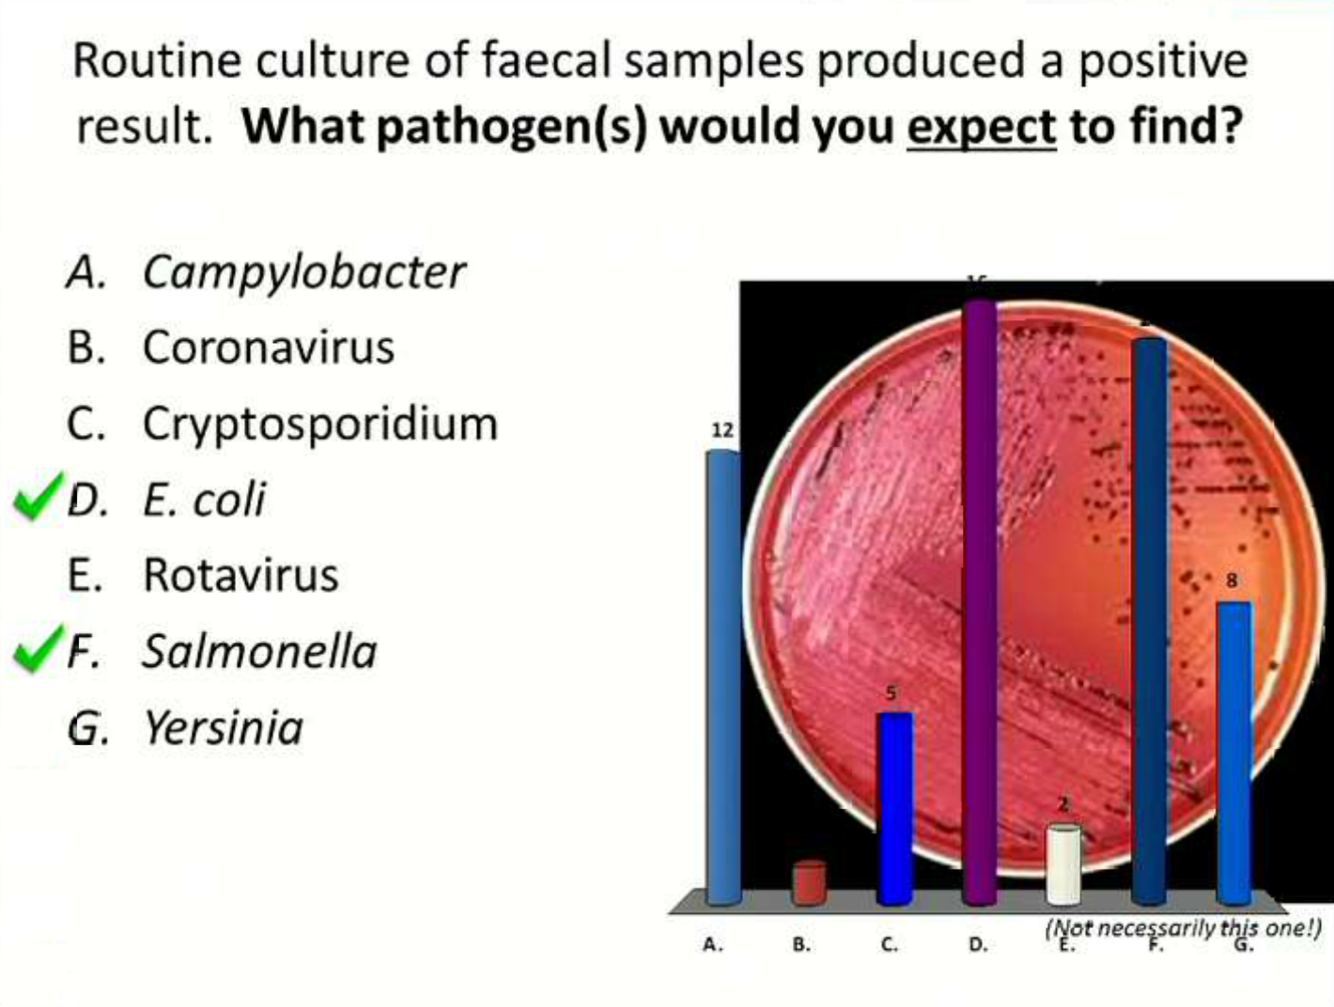

4 stages of acidosis
Cow is down- antibiotics and fluids
low rumen pH need to buffer
Compromise of gut wall if systemica effects

A. 5 liters of Hartmann’s IV quickly
B. 15 L of Hartmanns quickly IV
C. 2 L of hypertonic fluids IV and 20 L of electrolyte solution
D. 2 liters of hypertonic fluids and 20 L of water orally
E. 2 liters of hypertonic fluids and 20 L of water with 200g NaHCO3

blood volume of a cow? 40 L in 500 kg cow (8%)
Is she down because she is dehydrated?
She is down because she is acidotic and she is in shock, therefore circulatory collapse therefore not enough volume of fluid to fill capillaries….
Hartmann’s doesn’t treat acidosis well in cattle
* Animals that are dehydrated– extracellular space is dehydrated–idea of hypertonic solution is to draw fluid from the EC space to the IV space… where there is no fluid in the EC it can make them worse… however in cases of shock, hypertonic fluids are very useful… so hypertonic would be OK.
* So D or E??
A. 5 liters of Hartmann’s IV quickly
B. 15 L of Hartmanns quickly IV
C. 2 L of hypertonic fluids IV and 20 L of electrolyte solution
D. 2 liters of hypertonic fluids and 20 L of water orally
E. 2 liters of hypertonic fluids and 20 L of water with 200g NaHCO3

5 liters of Hartmann’s combined with flunixin.
5 liters to 40 L enough of a circulatory boost to get them going again. Don’t give too much end up with haemolysis.
** 2 L of hypertonic with electrolytes… reason for electrolytes… when you give hypertonic fluids IV and then oral fluids into the rumen… want to make easy path of fluid for fluids to get into the blood stream… putting electrolytes in will potentially slow that down
* use electrolytes in a dehydrated cow but not hypertonic solution for a dehydrated cow.
Diarrhoea last week, eating OK, not depressed, no straining or blood, normal temp, green poo, no grain, watery, sub mandibular oedema
A. Salmonella
B. Liver Fluke
C. JD
D. Simple indigestion
E. E. coli scours
F. BVD

Diet? Can always be change in diet of an individual cow because the cow before her didn’t eat and she got a double ration
* milk? dropping off
* JD?
* Parasitic tx? No.
Salmonella– unlikely– faeces would stink, depressed, first clinical sign is the cow goes off her feed, in herds with outbreaks– 20-40 cases… cows come into bail, if above 39C and not eating- treat
Liver fluke– could be, a bit old
JD- likely diagnosis, 7 is classic age, no other signs, sub mandibular oedema… Johne’s ELISA… Finding fluke eggs would not rule out Johne’s.
NOT Simple indigestion, E. coli scours, BVD– if you suspected could do ELISA on milk vat to check for antibodies but unlikely in this cow

A, B, C (within 1 week of suspicion so wait for the test)… can send the cow to knackery that has a positive ELISA but clinically normal
JD cause problems in humans?? Current thinking– people in both camps.
Incidence in WA CD, incidence in farmers is no different to the normal population


b. 12 DSE/ha
based on classes of animals have on the land
How can you tell farm is appropriately stocked? Based on French equation– below
** a bit on the lower side with stocking rate

What is a high total worm count in a lactating Merino ewe?

10-20,000 or more is a high total worm count
WHAT SHOULD YOU NEVER GIVE TO A GOAT?

GOATS ARE NOT LITTLE SHEEP

What are the presenting problems? DDX?
* diarrhoea
* Sudden death
* Illthrift
* Scours
* Large tail on mob
DDX: worms, nutritional scours, bacterial, protozoal, acidosis

Incomplete ossification– risk of crushing and damaging
Foals sometimes do have some incomplete ossification but this is an abnormal amount and it is impossible to keep from loading
next slide presenting problems


What do you do now?

Bacterial, viral or protozoa
Necropsy could help you decide… culture.. viral cause may not be able to tell– hard to get a fresh enough carcase
What do you do now?
Cleaning and rotating calves– hygiene
Sick ones out
Resus and fluid management– addressing dehydration and electrolyte imbalances

Calves with diarrhoea


Moderate skin tenting– 10% dehydration… 30-35 kg– needs 3 L of fluid
D.

Campy is hard to culture
you’d need to tell them you suspect specifically
Any more ideas?

Colostrum management
Rotavirus vaccine precalving




C


Nursing well
not crying persistently
being mothered well
sleeping together (no one on their own)


Birth weight
